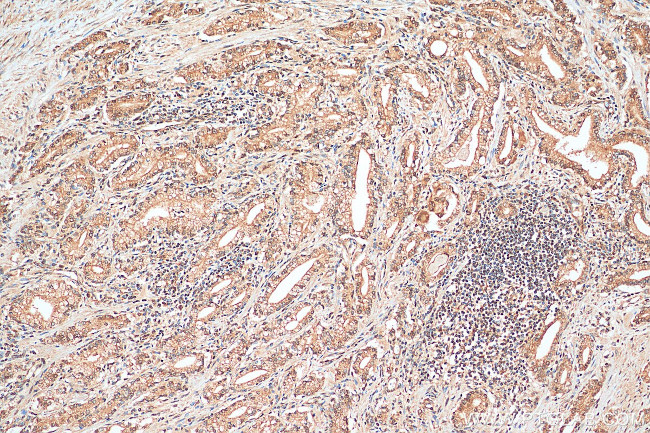
FOXO1 Antibody in Immunohistochemistry (Paraffin) (IHC (P))

Search
Proteintech
FOXO1 Polyclonal Antibody
{{$productOrderCtrl.translations['antibody.pdp.commerceCard.promotion.promotions']}}
{{$productOrderCtrl.translations['antibody.pdp.commerceCard.promotion.viewpromo']}}
{{$productOrderCtrl.translations['antibody.pdp.commerceCard.promotion.promocode']}}: {{promo.promoCode}} {{promo.promoTitle}} {{promo.promoDescription}}. {{$productOrderCtrl.translations['antibody.pdp.commerceCard.promotion.learnmore']}}
产品信息
18592-1-AP
种属反应
已发表种属
宿主/亚型
分类
类型
抗原
偶联物
形式
浓度
规格
纯化类型
保存液
内含物
保存条件
运输条件
产品详细信息
Immunogen sequence: SHSNDDFDN WSTFRPRTSS NASTISGRLS PIMTEQDDLG EGDVHSMVYP PSAAKMASTL PSLSEISNPE NMENLLDNLN LLSSPTSLTV STQSSPGTMM QQTPCYSFAP PNTSLNSPSP NYQKYTYGQS SMSPLPQMPI QTLQDNKSSY GGMSQYNCAP GLLKELLTSD SPPHNDIMTP VDPGVAQPNS RVLGQNVMMG PNSVMSTYGS QASHNKMMNP SSHTHPGHAQ QTSAVNGRPL PHTVSTMPHT SGMNRLTQVK TPVQVPLPHP MQMSALGGYS SVSSCNGYGR MGLLHQEKLP SDLDGMFIER LDCDMESIIR NDLMDGDTLD FNFDNVLPNQ SFPHSVKTTT HSWVSG (301-655 aa encoded by BC021981)
靶标信息
FOXO1 (FKHR, ForKHead Box 01) is a member in a subfamily of the forkhead homeotic gene family of transcription factors. Recent experiments have shown that FOXO1 can act as either a coactivator or a corepressor of nuclear receptor activity that is mediated through the LXXLL motif found in the carboxyl terminal region of the FKHR protein. Association of FOXO1 with PAX3 has been implicated in alveolar rhabdomyosarcoma. Recent studies link the anti-tumor activity of FOXO1, the process of autophagy and myogenic growth and differentiation. FOXO1 is the main target of insulin signaling that regulated the metabolic homeostasis in response to oxidative stress. FOXO1 binds to the insulin response element (IRE) with consensus sequence 5'-TT[G/A]TTTTG-3' and the related Daf-16 family binding element (DBE) with consensus sequence 5'- TT[G/A]TTTAC-3'. FOXO1 is a regulator of redox balance, osteoblast numbers and controls bone mass. Further, FOXO1 orchestrates the endocrine function of the skeleton in regulating glucose metabolism, and suppresses the transcriptional activity of RUNX2, an upstream activator of osteocalcin/BGLAP. In hepatocytes, FOXO1 promotes gluconeogenesis by acting together with PPARGC1A to activate the expression of genes such as IGFBP1, G6PC and PPCK1. FOXO1 is an important regulator of cell death acting downstream of CDK1, PKB/AKT1 and SKT4/MST1.
仅用于科研。不用于诊断过程。未经明确授权不得转售。
生物信息学
蛋白别名: forkhead box O1a; forkhead box O1A (rhabdomyosarcoma); Forkhead box protein O1; Forkhead box protein O1A; Forkhead in rhabdomyosarcoma; forkhead protein 1; forkhead, Drosophila, homolog of, in rhabdomyosarcoma; FOX01A
基因别名: Afxh; AI876417; FKH1; FKHR; Fkhr1; FOXO1; FOXO1A
UniProt ID: (Human) Q12778, (Rat) G3V7R4, (Mouse) Q9R1E0
Entrez Gene ID: (Human) 2308, (Rat) 84482, (Mouse) 56458